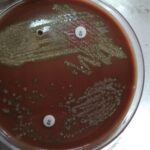

Category: Uncategorized
Urethral Swab Culture and Sensitivity Test-Introduction, Report, Clinical Significance, Common Pathogens, and Keynotes
 Introduction A Urethral Swab Culture and Sensitivity Test is a...
Introduction A Urethral Swab Culture and Sensitivity Test is a...
Sputum Culture and Sensitivity Test-Introduction, Report, Clinical Significance, Common Pathogens, and Keynotes
Introduction The Sputum Culture and Sensitivity Test is a diagnostic...
Introduction The Sputum Culture and Sensitivity Test is a diagnostic...
Slit Skin Smear Staining: Introduction, Preparation, Procedure, Result Interpretation, Application and Keynotes
 Slit Skin Smear Staining Introduction Slit Skin Smear Staining is...
Slit Skin Smear Staining Introduction Slit Skin Smear Staining is...
